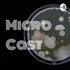
Micro Cast

Vamos discutir os temas do desenvolvimento sustentável de forma amigável, sem buscar verdades absolutas. Apresentado por: - Gustavo Soares, Administrador e Pós-Graduado em Gestão Estratégica da Sustentabilidade. - Renato Gatti, Engenheiro de Materiais e Pós-Graduado em Gestão Estratégica da Sustentabilidade.
| Publishes | Weekly | Episodes | 270 | Founded | 6 years ago |
|---|---|---|---|---|---|
| Language | Number of Listeners | Categories | NatureScience |

No Dia Mundial da Saúde (07/04), trazemos uma pauta urgente e emocionante. Você já parou para pensar no custo humano imposto pelas imensas distâncias percorridas por pacientes e pela grave falta de acesso a médicos especialistas no interior do país?A... more
Você já parou para pensar que os ciborgues não estão apenas na ficção científica, mas podem ser nós mesmos?
O Brasil é, hoje, um dos países com os maiores índices de Burnout no mundo. Nossa sociedade normalizou a hiperconexão, o trabalho excessivo e... more
E se a solução para a crise climática for… mexer no clima do planeta?Neste episódio do Beabá da Sustentabilidade, discutimos a geoengenharia — um conjunto de tecnologias que promete reduzir os impactos das mudanças climáticas, mas que também levanta ... more
95% das empresas estão deixando dinheiro na mesa (e perdendo a chance de mudar o mundo)!
Neste episódio vamos desvendar uma contradição que custa caro para a sociedade e para a reputação corporativa. Em uma era onde a agenda global exige ação, por q... more
Ter filhos em um mundo em crise climática é uma decisão ética? Ou ainda é possível construir um futuro de esperança para as próximas gerações?
Neste episódio do Beabá da Sustentabilidade, discutimos uma pergunta cada vez mais presente nas conversas ... more
O que você sente quando lê notícias sobre o aquecimento global ou vê imagens de desastres ambientais? Se a resposta for medo, paralisia ou uma sensação de impotência, você não está sozinho. Esse sentimento tem nome: Eco-ansiedade.Neste episódio do Be... more
O Rio Tapajós está em disputa: logística ou preservação?
Neste episódio 215, debatemos o futuro do Rio Tapajós. De um lado, o projeto do "Arco Norte" para o escoamento de grãos; do outro, a manutenção da vida e da biodiversidade na Amazônia.
Entend... more
Será que é possível unir design de alto desejo, conforto absoluto e um compromisso inegociável com o planeta? No episódio de hoje, mergulhamos na jornada de Isabela Chusid, a mente por trás da Linus — a marca que transformou a sandália de plástico em... more
How this podcast ranks in the Apple Podcasts, Spotify and YouTube charts.
Apple Podcasts | #14 | |
Apple Podcasts | #177 |

Listeners, social reach, demographics and more for this podcast.
| Listeners per Episode | Gender Skew | Location | |||
|---|---|---|---|---|---|
| Interests | Professions | Age Range | |||
| Household Income | Social Media Reach | ||||
Rephonic provides a wide range of podcast stats for O beabá da Sustentabilidade. We scanned the web and collated all of the information that we could find in our comprehensive podcast database. See how many people listen to O beabá da Sustentabilidade and access YouTube viewership numbers, download stats, audience demographics, chart rankings, ratings, reviews and more.
Rephonic provides a full set of podcast information for three million podcasts, including the number of listeners. View further listenership figures for O beabá da Sustentabilidade, including podcast download numbers and subscriber numbers, so you can make better decisions about which podcasts to sponsor or be a guest on. You will need to upgrade your account to access this premium data.
Rephonic provides comprehensive predictive audience data for O beabá da Sustentabilidade, including gender skew, age, country, political leaning, income, professions, education level, and interests. You can access these listener demographics by upgrading your account.
To see how many followers or subscribers O beabá da Sustentabilidade has on Spotify and other platforms such as Castbox and Podcast Addict, simply upgrade your account. You'll also find viewership figures for their YouTube channel if they have one.
O beabá da Sustentabilidade launched 6 years ago and published 270 episodes to date. You can find more information about this podcast including rankings, audience demographics and engagement in our podcast database.
Our systems regularly scour the web to find email addresses and social media links for this podcast. We scanned the web and collated all of the contact information that we could find in our podcast database. But in the unlikely event that you can't find what you're looking for, our concierge service lets you request our research team to source better contacts for you.
Rephonic pulls ratings and reviews for O beabá da Sustentabilidade from multiple sources, including Spotify, Apple Podcasts, Castbox, and Podcast Addict.
View all the reviews in one place instead of visiting each platform individually and use this information to decide if a show is worth pitching or not.
Rephonic provides full transcripts for episodes of O beabá da Sustentabilidade. Search within each transcript for your keywords, whether they be topics, brands or people, and figure out if it's worth pitching as a guest or sponsor. You can even set-up alerts to get notified when your keywords are mentioned.